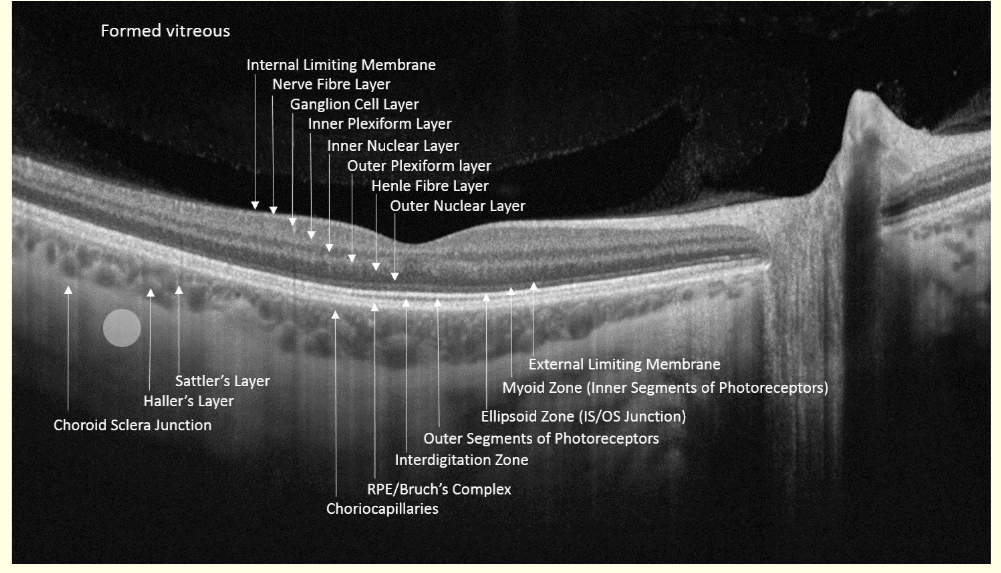
knowt flashcard image
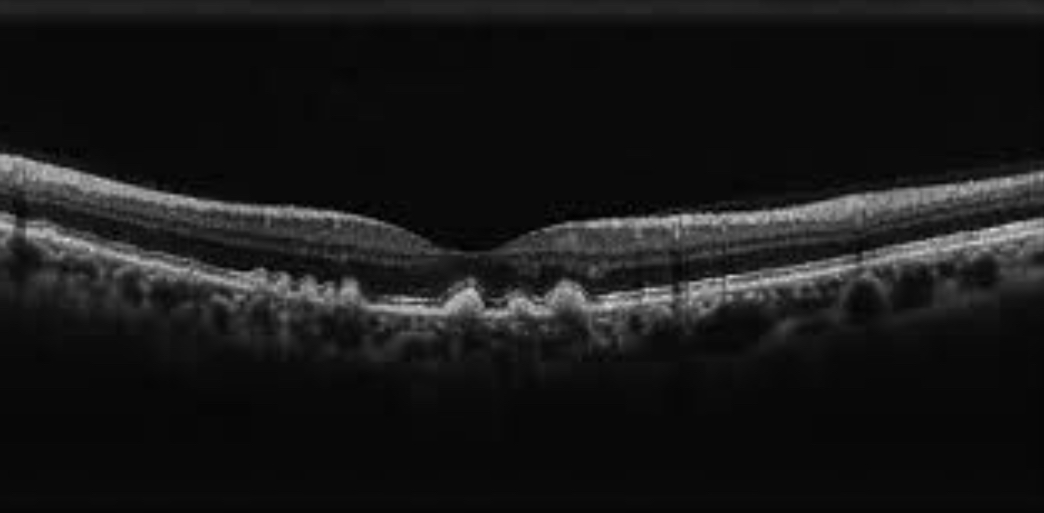
<p>What is this? </p>
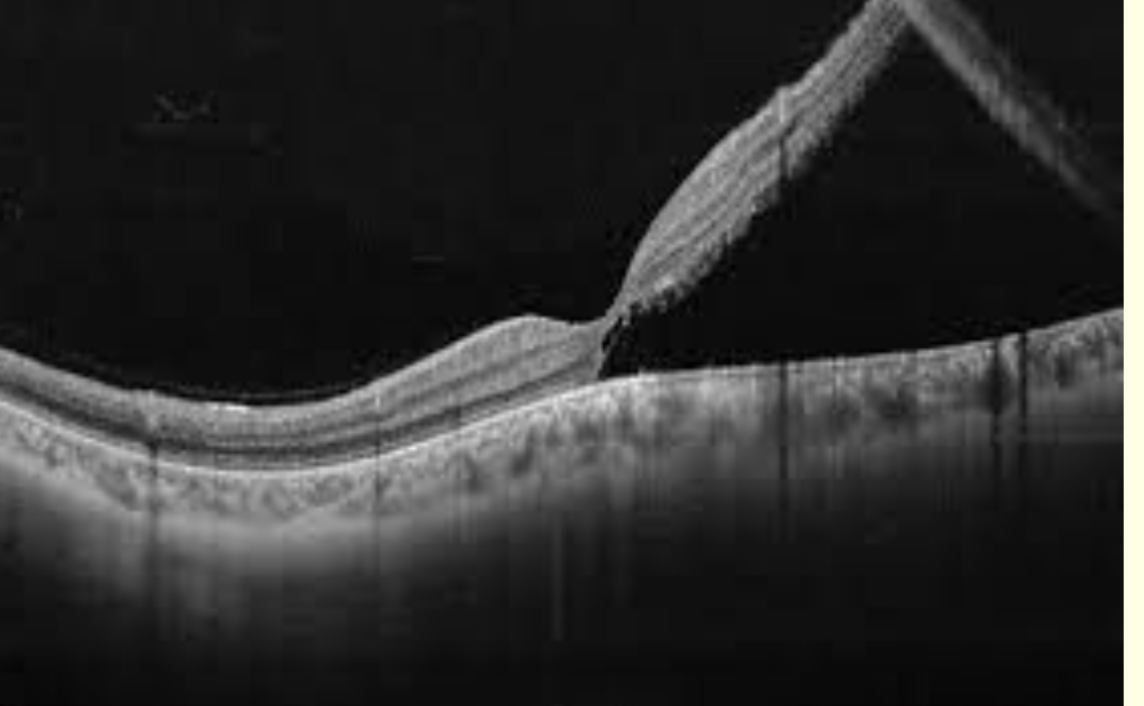
<p>What is this?</p>

1/39
Looks like no tags are added yet.
Name | Mastery | Learn | Test | Matching | Spaced | Call with Kai |
|---|
No analytics yet
Send a link to your students to track their progress
What are the basic principles of OCT imaging?
3D imaging technique with high spatial resolution
Large penetration depth even in highly scattering media
Based on measurements of reflected light from tissue discontinuities
Based on interferometry (interference between incident and reflected light)
Uses long wavelength light instead of of sound (3×10^8 m/sec)
How does the OCT image form?
layers and structures backscatter and reflect light at varying degrees
Refractive index variations cause contrast differences
Reflected light analysed
Image can be presented as 2D or 3D greyscale or false coloured image

Label this OCT scan

Which colours in colour coding OCT are most reflective?
White/red (bright colours)
Intermediate reflectivity - greeen
Low reflectivity - dark colours
How many scans to form a 2D B-scan?
30k A scans aligned In macular image
What can b-scans be used for?
3D image
What were early developments of OCT?
were time domain - time in difference in reflectance was analysed - slow
Spectral/fourier-domain (FD) - detects oscillations - high resolution and faster
What is the latest technology of OCT?
Swept source
longer wavelength of light - deeper pentretration of deeper layers
Better image past cataract
Faster - more scans in given time
What’s the resolution of OCT?
2-10 micrometers
What are uses of OCT in practice?
• Retina: Macular hole, macular oedema, retinal
detachment, epi-retinal membrane etc.
• Optic neuropathies, e.g. glaucoma: Nerve fibre layer thickness can be measured
• Anterior segment: Anterior chamber angle, cornea et
What are limitations of OCT scans in practice?
•Image affected by dense media opacities
•Px co-operation
• moving or blinking px will affect image
•Operator error - Must place instrument over pathology- be guided by fundus appearance
•Does not replace ophthalmoscopy

Label this diagram


Learn this

What is this?
Dry ARMD
What are characteristics of dry ARMD in an OCT scan?
•Characterised by drusen
•Bright, hyper-reflective elevations of RPE
•Retinal thinning

What is this?
Wet ARMD
What are the characteristics of wet ARMD in an OCT scans?
• Development of choroidal neovascularization (CNV) in sub-RPE space
• Detachment of RPE from choroid- ischaemia
• Symptoms metamorphopsia - waviness or
shimmering
What is the epiretinal membrane?
• Fibrous membrane forms along ILM
• This can shrink and cause the retina to wrinkle or pucker
• VA often not affected

What is this?
Retinal detachment
How do retinal detachment occour?
Neurnseosory retina separates from RPE
How can you view retinal detachment in OCT?
Px may have to
view peripheral
poinT
What are examples of diabetic retinopathy?
•Haemorrhages, exudates
•Inner retina
•Macular oedema
• Subretinal fluid
• Intra-retinal cysts

What is this?
Macular hole
What information can an OCT give you about the ONH?
•Quantitative measurements of optic disc topography and RNFL measurements
• Cup volume
• Disc area
• Cup and rim area
• C/D ratio
• RNFL thickness – yellow (borderline) and
red (abnormal - thinner than normal) - compared to normative database

What is this?
OCT of the anterior angle
Grade 3
Grade 1 -closed - refer
Should you do associated before dissociative tests?
Yes
Eg mallet unit before Maddox rod
Why do you view the anterior eye in an OCT?
•Assessment of A/C
angle
•Corneal pathology
•Contact lens fittinG

What is this and what does it do?
OCT-A optical coherence Tomography angiography
•Shows blood flow in retinal vessels
• Ability to detect and monitor vascular anomalies
•Unlike fluorescein angiography, it does not show leakage from vessel
What is ultra wide field (UWF) imaging?
•Traditional cameras capture 30-50 degrees
•Photomontages were created to increase
the FOV beyond this
•Time-consuming
•Demanding of px
How many degrees can UWF imaging view?
Up to 200 degrees possible

Learn this


Learn this

What is the technology behind confocal Asher scanning microscopy?
The illuminating system is a laser beam with cross section 10-20μm
• The viewing system is a photocell
• Horizontal and vertical mirrors allow fast scanning of the laser beam
• Reflected light from the retina builds up an image of the Fundus
• Confocal means that v small viewing apertures restrict the view to the area directly illuminated by the laser
• Changing the focus allows different layers to be
visualise
What do green lasers scan from?
The sensory retina to the pigment epithelial layers
Accentuates retinal blood vessels
What do the red lasers scan for?
RPE to choroid
Accentuates choroidal circulation
What are blue lasers used for?
fluorescein angiography procedures
What are infrared lasers used for?
indocyanine green angiography procedures
What are limitations of Optos?
•Retinal distortion in periphery
•‘Map effect’
•In Optos, the mirror is ellipsoid
•Lash artifact
•Ora serrata not visible – indirect with scleral indentation still needed
What are some clinical uses of optos?
• Peripheral retinal disease and degenerations
• Holes, tears, detachments
• Diabetic retinopathy
• Identifies non-perfusion and neovasc
• Retinopathy of prematurity
• Retinal vein occlusion
• Identifies peripheral retinal ischaemia, neovasc
and macular oedema
• Posterior uveitis

What technique is being used here?
Opto -map